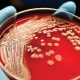

Canlıların nesillerini sürdürmek amacı ile kendilerine benzer yapı ve özellikte yeni canlı meydana getirmelerine üreme denir. Mikroorganizmalarda nesillerini devam ettirebilmek için üremek ve çoğalmak zorundadır ancak mikrobiyal üreme, popülasyonda ki hücrelerin büyüklüğünü değil popülasyonda ki hücrelerin sayısında ki artışı ifade eder. Bu nedenle üreme yerine çoğalma kelimesi kullanılacaktır. Mikroorganizmalarda çoğalma şekli cinse, türe ve hatta çevre koşullarına göre değişiklik gösterebilmektedir. Mikroorganizmalarda görülen genel çoğalma şekilleri aşağıda verilmiştir.
Mikroorganizmalarda genel olarak iki çoğalma şekli görülür. Bunlar eşeyli ve eşeysiz çoğalma şeklindedir. Eşeysiz çoğalma dendiğinde iki ayrı cinsten hücrelerin herhangi bir şekilde birleşme olmaksızın tek bir hücrenin çoğalması anlaşılır. Eşeyli çoğalmada ise iki farklı genetik karakterdeki hücrenin birleşerek farklı karakterdeki hücrelerin oluşmasıdır. Eşeysiz çoğalmada aynı genetik karakterde hücreler oluşurken, eşeyli çoğalmada ise farklı genetik karakterde hücreler oluşur. Dolayısıyla eşeyli çoğalma genetik çeşitliliği sağlar.
Eşeysiz Çoğalma
Eşeysiz çoğalma; vejetatif çoğalma ve sporla çoğalma şeklinde olmaktadır. Sporla çoğalma daha çok funguslarda görülürken vejetatif çoğalma ise maya ve bakterilerde görülmektedir.
Vejetatif Çoğalma: Vejetatif çoğalma mikroorganizmalardan hem ökaryotlarda hem de prokaryotlarda görülen çok yaygın bir çoğalma şeklidir. Çevre koşulları uygun olduğu sürece mikroorganizmaların büyük bir bölümü yalnızca vejetatif yoldan çoğalır ve neslini sürdürür. Vejetatif çoğalma iki şekilde olmaktadır. Bunlar ikiye bölünme ve tomurcuklanma şeklindedir. Tomurcuklanma, mayalarda çoğalma genellikle hücrenin tomurcuklanması ile olmaktadır. Mayaların çoğalması ile ilgili bilgiler ilerleyen bölümlerde daha ayrıntılı verilecektir. İkiye bölünme ise daha çok bakterilerde görülürken bazı maya türlerinde de görülebilir.
İkiye Bölünme: Çoğu bakteride tek bir hücrenin gelişimi iki yeni hücre oluşuncaya kadar devam eder, bu olaya ikiye bölünme denir. Bakteriler ve riketsiyalar genellikle ikiye bölünerek çoğalırlar.
Silindirik veya çubuk şeklindeki bakterilerde bölünme uzun eksene dik yönde olur. Koklarda ise herhangi bir çap yönünde meydana gelebilir. Bu işlemler yapılırken hücre içinde özellikle nuklear bölgede bir organizasyon görülür. Toplu hâlde bulunan nukleus orta bölgede uzamaya başlar. Nukleus, sitoplasmik membrandaki özel yere (muhtemelen mesosom) bağlanarak replikasyona başlar. Replikasyon tamamlanınca hücre duvarından içeri doğru ve karşılıklı olarak bir bir septum oluşumu görülür. Buna sitoplazmik membran da iştirak eder ve septumlar uzayarak hücreyi ortasından iki kardeş mikroba ayırır. Bu iki hücre ya birbirinden ayrılarak tam bağımsız hâle gelirler ya da birbirlerine bitişik olarak kalırlar. (Streptokok, Streptobasil, flamen- Töz Formlar).
Yukarıdaki şekilde çubuk şeklinde bir bakterinin ikiye bölünmesi gösterilmektedir. İkiye bölünmede şu aşamalar gözlemlenir.
1- Bölünme başlamadan önce, iki kardeş hücreye yetecek kadar organik ve inorganik maddelerin sentezini gerçekleştirir.
2- DNA kendisini kopyalayarak miktarını iki katına çıkarır (DNA’nın kendisini kopyalamasına replikasyon denir.) Bu aşamadan sonra hücrede enine büyüme gösterir.
3- Bölünecek hücrenin orta kısmından ara bölme (septum) oluşur. DNA’lar yeni hücrelere geçmek için birbirinden ayrılır. Ara bölmenin oluşması sonunda iki yavru hücre oluşur. Oluşan yavru hücreler birbirinin aynı genetik karaktere sahiptir.
E. coli’nin bazı mutant tiplerinde verici (erkek), alıcı (dişi) hücrelerin bulunduğu ve konjugasyon sonucunda verici hücreye ait genetik materyal alıcı hücreye geçer. Buna rekombinasyon adı verilir. Bu bir çoğalma şekli değil, gen aktarım mekanizmasıdır. Bu olay eşeyli çoğalma olmamasına karşın bakterilerde genetik çeşitliliği sağlar. Bu bakterilerde genetik çeşitliliği sağlayan bir olaydır.